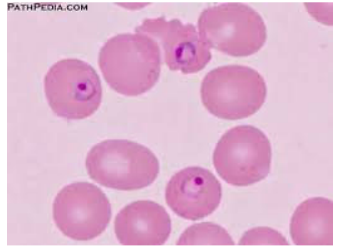
Enunciado 3891576-1

Foram encontradas 1.348 questões.
- Tecnologia das ConstruçõesSistemas e Elementos ConstrutivosMateriais para Construção
- Tecnologia das ConstruçõesSistemas e Elementos ConstrutivosSistemas EstruturaisEstruturas de Concreto
Entre os diferentes traços de concreto a seguir (em termos de proporção de materiais), qual deles deve fornecer a maior resistência à compressão, considerando que os mesmos materiais estão sendo utilizados?
Provas
Considerando o princípio da equidade do SUS:
Avalie as assertivas a seguir e assinale (V) para as verdadeiras e (F) para as falsas:
( ) Assistência de saúde igualitária depende das necessidades, diversidades e especificidades de cada cidadão ou grupo social.
( ) A equidade se evidencia no atendimento aos indivíduos de acordo com suas necessidades, oferecendo mais a quem mais precisa e menos a quem requer menos cuidados.
( ) A palavra equidade pode ser definida como uma justiça natural; disposição para reconhecer imparcialmente, o direito de cada um, isso significa reconhecer que todos precisam de atenção, mas não necessariamente dos mesmos atendimentos.
( ) Um prático exemplo de aplicação da equidade ocorre em atendimentos de urgência em hospitais, a prioridade no atendimento é definida por critério de ordem de chegada, sem haver prioridade de cada caso.
Marque a alternativa que apresenta a sequência CORRETA, tendo em vista a ordem de cima para baixo.
Provas
A Política Nacional de Humanização (PNH) deve se fazer presente e estar inserida em todas as políticas e programas do SUS.
I- A Humanização do SUS aposta na inclusão de trabalhadores, usuários e gestores na produção e gestão do cuidado e dos processos de trabalho.
II- Incluir os trabalhadores na gestão é fundamental para que eles, no dia a dia, reinventem seus processos de trabalho e sejam agentes ativos nas mudanças no serviço de saúde.
III- As rodas de conversa, o incentivo às redes e movimentos sociais e a gestão dos conflitos gerados pela inclusão das diferenças, são ferramentas experimentadas nos serviços de saúde a partir das orientações da PNH.
Está(ão) CORRETA(S) a(s) afirmativa(s)
Provas
A Leishmaniose é uma doença infecciosa, porém não contagiosa, causada por parasitas do gênero Leishmania.
Avalie as afirmativas a seguir e assinale (V) para as verdadeiras e (F) para as falsas:
( ) Esses parasitas vivem e se multiplicam no interior das células que fazem parte do sistema de defesa do indivíduo, chamadas de macrófagos.
( ) A leishmania tegumentar é uma doença sistêmica, pois acomete vários órgãos internos, principalmente o fígado, o baço e a medula óssea.
( ) O teste de Montenegro, um dos exames solicitado em caso de suspeita de leishmania, é uma reação intradérmica de hipersensibilidade retardada que revela a presença de resposta imune celular ao parasita.
( ) O teste confirmatório para leishmania visceral canina é feito por meio da técnica de PCR, que permite a detecção de anticorpos no plasma sanguíneo, o antileishmania.
Marque a alternativa que apresenta a sequência CORRETA, considerando as afirmativas de cima para baixo.
Provas
As Hemofilias A e B são distúrbios congênitos da coagulação com importância clínica, pois têm uma tendência grave e duradoura de sangramento excessivo, que ocorre quase exclusivamente em homens e segue o padrão de herança ligado ao cromossoma X. Esta síndrome é produzida, especificamente, pela deficiência de um fator de coagulação. No caso da hemofilia B, está ligada à deficiência do fator:
Provas
As informações a seguir são a respeito de uma parasitose humana:
• No hemograma, a presença de anemia e eosinofilia, associado a um quadro gastrointestinal suspeito, é uma dica importante para o diagnóstico.
• O diagnóstico é feito através da detecção de ovos do parasita nas fezes.
• A contaminação se dá por contato direto da pele com o solo contaminado ou por ingestão da larva presente no ambiente.
• Após penetrar a pele, a larva alcança os vasos sanguíneos e viaja até os pulmões, onde permanecerá por alguns dias. Quando o paciente tosse, o parasito pode ser lançado em direção a cavidade oral inadvertidamente deglutida.
• Se a contaminação inicial não tiver sido pela pele, mas sim por ingestão acidental da larva, essa primeira parte do ciclo não existe, indo o parasito diretamente para o trato gastrointestinal.
• O paciente pode apresentar náuseas, vômitos, diarreia, cansaço, aumento de gases e dor abdominal.
A alternativa correspondente às informações apresentadas é:
Provas
Durante a rotina laboratorial em um hospital, um biomédico observa, na leitura de uma lâmina hematológica, a presença de um protozoário. Procurou saber com o médico o histórico do paciente, e ele relatou que o paciente chegou de viagem da região norte com queixas de febre alta, tremores, calafrios, sudorese e dor de cabeça, tais sintomas podendo ocorrer de forma cíclica.
Disponível em: https://www.facebook.com/story.php?story_fbid=3245902992100755&id=380834805274269&mibextid=xfxF2i&rdid=dmWcEpl98x4j8ROl. Acesso em: 20 jul. 2024. Adaptado.
Com base nessas informações e na figura, que tipo de protozoário foi identificado:
Provas
As espécies Neisseria tem como característica morfológica serem diplococos Gram negativos, não esporulados mais achatadas nas laterais, dando a forma de rins e dois grãos de feijão unidos por uma ponte. A Neisseria meningitidis, também chamada de meningococo é responsável pela meningite meningocócica, infecção sistêmica grave com coagulação intravascular disseminada(CIVD) e elevada mortalidade, podendo causar em associação outras infecções (conjuntivite, artrite, sinusite e pneumonia). A transmissão se faz por vias aéreas.
Avalie as afirmativas a seguir e assinale (V) para as verdadeiras e (F) para as falsas:
( ) O meningococo tem como principal fator de virulência a cápsula polissacáridica, que é antifagocitaria. Uma vez dentro dos fagócitos, os meningococos são facilmente destruídos.
( ) A cultura de Neisseria meningitidis para pesquisa de portadores (swab de orofaringe) necessita da utilização de meio um seletivo de ágar sangue e para LCR um meio enriquecido de ágar chocolate.
( ) É um pouco mais tolerante a variações de temperatura, mas recomenda-se para transportes ambientes com O2.
( ) A caracterização de Neisseria meningitidis para LCR e outros fluidos pode ser feita pela técnica de aglutinação com partículas de látex, que é rápida, com boa sensibilidade, especificidade e permite a tipagem dos principais tipos prevalentes de meningites.
Marque a alternativa que apresenta a sequência CORRETA, considerando as afirmativas de cima para baixo.
Provas
A prova da coagulase verifica a capacidade de um microrganismo coagular o plasma através da enzima coagulase. Geralmente é usada para identificação de qual microrganismo?
Provas
Como princípio básico desta técnica, está a identificação, quantificação e separação de populações celulares, utilizando três sistemas: de fluidos, ótico e eletrônico. Uma fonte de laser incide sobre as partículas suspensas na amostra, fornecendo dados relativos ao seu tamanho e à sua granulosidade. No processamento das amostras para análise, os epítopos expressos, também chamados de clusters de diferenciação ou CDs, são marcados com anticorpos monoclonais e fluorocromos, ligando-se à superfície da célula ou ao interior delas.
Assinale a alternativa que apresenta a metodologia descrita.
Provas
Caderno Container